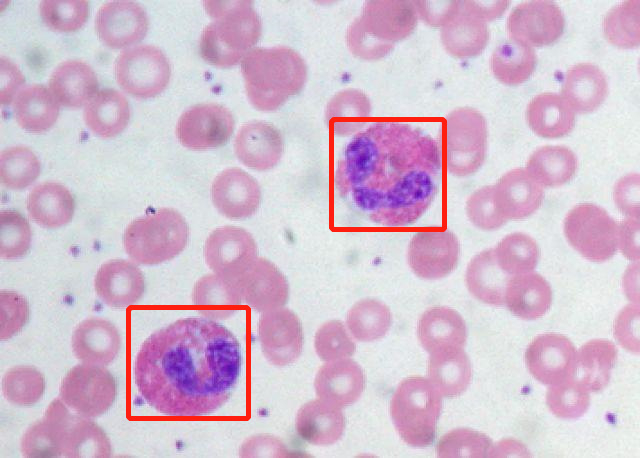

手机访问:wap.265xx.com播放超2亿!这部神作,每个上有老、下有小的成年人都该好好看看!
大家好啊!昨天给大家开团了筹备已久的体检套餐点这里回看),本来是很值得开心的事情,但结果居然是:
我回私信回到要生气了!
具体原因是这样的。昨天在体检套餐发布以后,很多朋友都发私信跟我讨论体检套餐的搭配逻辑以及项目情况,这些朋友对于体检本身是懂的,更是知道体检本身的重要性。
但是当我问到:「你上一次体检是什么时候?」,得到的答复却是,「已经好几年不去体检了」,有些朋友说是因为平时带娃太忙,有些朋友则说,「每个中年人,谁还不是个上有老下有小的“三明治”,谁又病得起呢?」
而当我问这一次有没有买我筹备的体检套餐时,得到的回复依然是「」。我看情况安排
说实话,聊到这里我真的生气了,也很伤心!
推这个体检套餐,我最希望的就是大家把身体重视起来,最不希望的,就是给大家传递焦虑。但是:
不知道≠不存在
在我们第一天分享探店经历的时候,公司小伙伴就打趣儿地说过:「总感觉不去体检就万事大吉,一去体检就快要死了一样」。但是,
不去体检就真的万事大吉了吗?
有多少血淋淋的案例告诉我们,一次晕倒送医院、一次头痛送医医院,就可能是一次无可挽救的疾病确诊。这样的案例数不胜数,却通常被我们一句轻描淡写的「好端端的一个人,怎么说倒就倒了呢?」,就给解决掉了。
体检真的很重要,并且要养成每年体检的习惯!就好像我至今仍然庆幸去年和今年的体检都帮助我及早发现问题,将问题扼杀在摇篮期!
只有讳疾忌医,才会让人“不生病则已,一生病则大病”,所有的疾病都不是突如其来的,病从浅中医的道理,大家不要再懂装不懂了。
因此,我今天特别想跟大家介绍一部央视引进的健康科普动漫——《工作细胞》,带大家换个角度认识身体里的秘密。
全部系列我都看完了,基本上是边看边唏嘘,我们身体有那么多细胞在为我们服务,而我们是爱护它们,还是滥用它们,都在这部动画片里,被描述得赤裸裸、明明白白!

《工作细胞》一共有两季,我也帮大家把两季的资源都找好了,看到文末即可获取。
讲内容前,先给大家讲讲《工作细胞》到底有多火爆。作为面向全年龄段的科普动画,它早在2018年就“出了圈”,收到了无数医学博主和媒体的点赞,更是一举拿下了上海电视节白玉兰奖的最佳动画剧本奖。

不仅评分高达9.6,播放量超2亿,还被央视引进作为春节档动画片,可见它的质量和口碑到底有多高。

这部动画主要讲了人体内的红血球、白血球、巨噬细胞等细胞,为了保护我们的身体,不断和细菌病毒战斗的故事。

画风细腻Q萌,情节既温情又热血,最重要的是,它帮助我们换一个视角去看我们身体里的秘密,让我们感慨,也让我们惭愧,是时候反思自己对自己身体健康的用心程度了!
01 每个细胞都在勤勉为我们工作啊!
有个资深影评人说过,日本动漫最神奇的一点是就是:万物皆可拟人化。而在这部动画里,我们体内的红细胞、白细胞、血小板等等,也都化作一个个鲜活立体的人物,我们的身体,就成了他们赖以生存的“生命世界”。

在这个如工厂般庞大精密的世界里,生活着37兆2千亿个细胞,他们每天都在精神十足地工作,让整个世界运作得井然有序...

首先出场的,是一位叫“红细胞”的女生。
她是一个兢兢业业的快递员,每天在体内四处奔走送货。

如果你细看她手上抱的货物,就会发现那是我们正在呼吸着的氧气。

将氧气输送到身体各处的细胞中,并将一部分二氧化碳输送到肺部,就是红细胞的工作。

但作为新手的红细胞妹妹,却迷迷糊糊地搞不清路线,推着一箱子二氧化碳四处找肺部。

结果不是被静脉瓣膜拦截,就是被淋巴管的哨兵喝止。

摸到脾脏就算了,一路瞎转,竟然还跟细菌打了个照面。
“确认过眼神,你不是对的人”

这个像异型怪兽一样的细菌,就是著名的肺炎球菌。

它会侵入肺细胞并且破坏红血球,也是最坏能够破坏脑部的病原体,不仅可以导致儿童肺炎,而且还是引发脑膜炎、中耳炎等疾病。

有细菌出现的地方,当然就有我们时刻冲在一线的白细胞(中性粒细胞)战士。

看似冷冰冰的他们,却是忠心耿耿保护我们身体的黑骑士。哪里有危险,哪里就有它们冲锋在前的身影。

像身体出现的任何外部入侵的细菌、病毒异物,都是它们首要清理的目标。

看过酷酷的拟人版白细胞,瞬间就在脑海里记住了它在现实里的样子和功能:能吞噬异物或产生抗体,帮助机体防御感染。

除了反应迅捷的白细胞,我们身体里还有很多其它防御部门。
比如战斗力更加强悍的杀伤性T细胞,它们直接听命于辅助T细胞指挥官,可以反复杀伤病毒异物,而本身不受损伤。

现实里的它们,也像隐藏在黑暗中的“杀手”一样,消灭掉产生特殊抗原反应的目标细胞。

还有这位笑容和蔼可亲的小姐姐。

它其实是巨噬细胞,负责捕杀细菌病毒等异物,帮助机体开展修复工作,并清除死去的细胞和细菌。

当然,人气最高的,莫过于我们的血小板。
他们是一群超级萌的小朋友!总是集体行动,擅长修修补补,功能强大。

别看人家小小一只,集合起来就是一支不可忽视的队伍呢~
当血管发生损伤时,它们就带着血纤蛋白和凝血因子出来堵住伤口。

堵住伤口的同时,也堵死了更多细菌进来的通道,红细胞得以安全地留在体内,白细胞也可以专心致志地绞杀留存体内的病毒细菌。

血小板们工作起来那个认真劲头,真的太可爱了。

制作组之所以会把血小板设定成幼儿园的小朋友,也是参照了现实中,血小板是最小的血细胞这个定义。

看到这里大家应该也发现了,整部动漫在最开始的人物设定上,就是对照着现实中的细胞形态来制作的。

勤勤恳恳的红细胞、满头是刺的肺炎球菌、冲锋陷阵的白细胞、小巧团结的血小板...

他们的形象已经在我们的脑海中形成了强力的联结,即使不看书,也能轻松回想起他们的特点和作用。这就是《工作细胞》最先吸引我的地方。
值得一提的是,上面讲到的人物设定小巧思,只是片中的冰山一角。
比如在第四话《食物中毒》中,帅到爆炸的嗜酸性粒细胞,在剧中是一个双马尾妹妹。你猜怎么着?我们体内的嗜酸性粒细胞,还真的是“双马尾”!

本体长下图这样,图中那俩大个的就是。我们可以看到嗜酸性粒细胞的细胞核呈非常明显的双叶。
不仅双马尾是从这里来的,就连衣服的主色调,也是按照显微镜下的成像来设定的,简直细到离谱。
又比如第二话《擦伤》里的血栓,积聚的白细胞和红细胞被纤维蛋白紧紧地捆在了一起。

这个画面,也高度还原了真实的血栓图片,我现在一看到这张图片,就会想起红白CP被捆在一起的画面

▲扫描电镜下的血栓图▲
这些处处是伏笔的构思,让我们不仅能学到最基础的生物定义,还能在不知不觉中掌握更细致、具体的原理和现象,真的令人叫绝。
02 身体机能到底是怎么样运作的?
我们体内的细胞,当然不会在流水线上岁月静好,我们的喜怒哀乐、日常活动、生病衰老,背后都是他们在不断变化和行动所构成的。
而这些变化和原理,就被《工作细胞》就用形象生动的故事演绎了出来。
你知道我们为什么会感冒吗?
当病毒侵入人体,被病毒寄生的细胞就会不断增加,引起我们的发烧、疼痛。在动漫里,这些细胞就变成了“僵尸”,而且还在不断壮大。

这时只靠白细胞来杀菌肯定是远远不够的,还需要杀伤性强的巨噬细胞,也就是我们刚刚提到的白衣小姐姐。

关键时刻,巨噬细胞扛起大刀,直接消灭掉大量的流感病毒。

当然,巨噬细胞的力量还是有限的,所以她在发现病毒后,还会通知树突状细胞小哥哥, 让他传话给各个器官,让杀手T细胞立刻赶来支援。

刚刚提到的黑衣战士杀手T细胞,就会在病毒难缠的时候,迅速出手啦。

在一群杀手T细胞中,还有一部分叫作“记忆T细胞”,看他手里的小本本,你就知道他的工作是什么了。

对于每次的反攻,记忆T细胞可是会做记录的,方便下次的处理能够更高效。这就是为什么我们得了感冒后,一段时间内都不会再得感冒的原因。
再提问:你知道我们为什么会打喷嚏吗?
还记得刚刚讲到的肺炎球菌吗?这家伙入侵了身体后,就会依靠身上的荚膜保护自己。

仗着自己无法被直接消灭,卑鄙的球菌向着白细胞步步紧逼。

没想到,白细胞其实是在把细菌引到支气管,直接捕获住。

最终,细菌乘坐“喷嚏一号”火箭,被发射出体外,这就是“打喷嚏”的全过程,真是太形象了。

看到片中给出的解释,我们总算彻头彻尾明白,打喷嚏就是对灰尘、细菌这些异物产生的排异反应,脏东西是通过一个个喷嚏排出去的。

这也提醒了我们,在疫情防控的特殊时期,在公开场合更要戴好口罩、注意飞沫。
怎么样,这种夸张而不失真的原理呈现,是不是比教科书上的更有趣,更好理解呢~
03 多一分了解,早一分预防
如果说前两个特点是让孩子在刺激有趣的故事里学习基础的人体健康知识,那么《工作细胞》中真实无比的疾病故事,则教会了孩子健康的重要性。
除了常见的感冒、擦伤、中暑等话题,《工作细胞》的第七集还提到了一个大家需要格外警惕的疾病——癌症。
今天,大部分人的生活水平提高了,癌症却越来越常见。不得不说,我们对癌症多一分了解,就可以早一分预防。
根据世界卫生组织发布的报告,2020年有1000万人死于癌症,全世界1/5的人在其一生中都会罹患癌症。此外,每年约40万儿童确诊癌症。

动画中,可怕的癌细胞被拟人成懵懂的孩子。因为人体内每时每刻都在细胞分裂,分裂过程中难免会产生变异细胞。

再想想人体内细胞数量之庞大,换句话说,人体内每天都会产生癌细胞。

同时,体内也会有无数的免疫细胞在“巡逻”,一旦发现敌人(变异细胞),就会“群起而攻之”,保证身体的健康。

但出现癌细胞并不代表人就得了癌症。在动画中,癌细胞从懵懂孩童时就被当成异类,“明明我什么也没有做错,不过是复制出错,为什么大家要把我当成坏人呢?”

每天东躲西藏的日子并不好过。癌细胞的心理越来越扭曲,同时也为了吸食营养伤害了正常细胞,成为强大的“黑暗势力”。

即便癌细胞再“可怜”,免疫细胞也不会轻易放过它。
因为一旦免疫细胞“屈服”,变异细胞就会大量繁殖不受控制,违反身体的规律快速增殖,夺取养分,破坏其他正常的组织,最后逐步形成肿瘤。

每当看到这种“干货”知识点,我都会暂停下来做些笔记,也能给娃适当科普。

关于癌细胞的这一话,最终以免疫细胞的胜利结束。
不仅因为正常细胞的奋力合作,还有在屡战屡败之后,这个身体的主人一直保持乐观、心态好,激发了NK细胞的活性化。

但可惜的是,在现实世界中,由于不注意身体,积病已久,很多人罹患癌症后身体的免疫系统很快被破坏,也就难以打败癌细胞。
我跟娃看完这一集的时候,也是认认真真地给他科普了容易导致癌症的习惯和行为,以及我们可以做些什么来预防癌症。他听完也是若有所思地给我点了点头,不知道他能吸收多少,但有所收获,有所预防,总归是好的。
当我们在熬夜、暴饮暴食时,有没有想过身体里的可爱细胞们呢?
当看到身体里所有细胞都在拼死保护我们,又有什么理由不爱惜自己的身体呢?
当看到NK细胞对着癌症力挽狂澜的时候,我们怎能忘记乐观和积极的力量呢?
这部动画不仅仅是在向我们科普,同时也是在告诉我们一个人生哲理:
当你孤独绝望的时候,请记住,有37兆2千亿个细胞只为你一人而活。
身体健康,比什么都重要。
写在最后:
上面就是我对《工作细胞》的全解读。答应我,一定要去看看。每一个上有老、下有小的成年人,都不能忽视对自己健康的重视。资源我都整理好了,大家点个“赞”+“转发”,私信我回复“工作细胞”即可获取。定期体检,呵护自己,这部不可多得的健康科普动画片,会帮助你领悟健康的真谛。
昨天给大家推荐的爱康体检套餐,我再给大家强调一下,我是按照全身“扫描“一遍的大原则,帮大家搭配搭配好的中青年和老年体检套餐,买一送一,也支持双人拼团,可以来添加芝芝进社群拼:mengyataotao我们都知道体检项目是难以穷尽的,只要想做,那身体任何一个部位都可以做至少十多个项目,但是前提是:是否真的有这个必要?
而我给大家搭配的这两个套餐,是我独家给大家搭配的,里面的体检项目都是刚需的,而且没有冗余,如果大家对于项目又不理解,可以在文末留言告诉我,我来帮大家一一解答;如果你相信我的判断和套餐那配逻辑,那么直接拍下去体检就对了!
毕竟,健康管理的第一要素,不是理解体检的重要性,而是行动起来,带上自己的队友和长辈,带上自己关心在乎的亲朋好友,从今年开始把体检做起来!
上一篇:刘恺威颖儿《画皮2》圆满结局颖儿最终牵手走江湖
下一篇:原创一拳超人148:黑光对虫神力量的冲突,琦玉轻松完虐龙级怪人波奇
最近更新科技资讯
- 22年过去了,《透明人》依然是尺度最大的科幻电影,没有之一
- 人类基因编辑技术及其伦理问题
- 不吹不黑,五阿哥版的《嫌疑人》能过及格线
- 论Lacan心理公众号的“双标”特质
- 猎罪图鉴:犯罪实录 女性伦理
- 清入关的第一位皇帝是谁,清朝入关后有几位皇帝?
- 描写露台的优美句子
- 谭德晶:论迎春悲剧的叙事艺术
- 中秋节的好词好句
- 《三夫》:一女侍三夫,尺度最大的华语片要来了
- 赛博朋克的未来,在这里
- 文件1091/721/2A:反概念武器实体的一封信件
- 尤战生:哥伦比亚大学点点滴滴
- 韩国最具独特魅力的男演员(安在旭主演的电视剧有哪些)
- 乃至造句
- 请保护好我们的医生,他们太难了
- GCLL06-土木工程的伦理问题-以湖南凤凰县沱江大桥大坍塌事故为例
- 黄金宝典:九年级道德与法治核心考点必背篇
- 【我心中的孔子】伟大的孔子 思想的泰山
- CAMKII-δ9拮抗剂及其用途
- 选粹 | 郑玉双:法教义学如何应对科技挑战?——以自动驾驶汽车为例
- 苍井空37岁宛若少女,携子送祝福遭热讽,下架所有视频母爱无私
- 日韩新加坡怎么对待影视剧中的裸露镜头
- 中西方文化中的颜色词
- 土豪家的美女摸乳师——关于电影《美人邦》